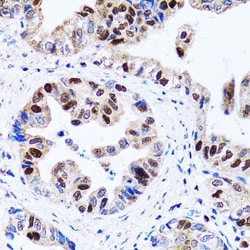
Invitrogen UHRF1 Polyclonal Antibody 100 &mu;L | Buy Online | Invitrogen&trade; | Fisher Scientific
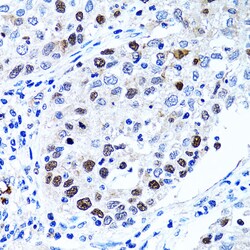
Invitrogen UHRF1 Polyclonal Antibody 100 &mu;L | Buy Online | Invitrogen&trade; | Fisher Scientific

Learn More
Invitrogen™ UHRF1 Polyclonal Antibody


Description
This antibody detects endogenous protein at a molecular weight of 90 and 110 kDa. Purity is >95% by SDS-PAGE.

Specifications
Specifications
| Antigen | UHRF1 |
| Applications | Immunohistochemistry (Paraffin), Western Blot, Immunocytochemistry, Immunoprecipitation, Western Blot |
| Classification | Polyclonal |
| Concentration | 1 mg/mL |
| Conjugate | Unconjugated |
| Formulation | PBS with 50% glycerol and 0.02% sodium azide; pH 7.2 |
| Gene | UHRF1 |
| Gene Accession No. | Q8VDF2, Q96T88 |
| Gene Alias | Ac2-121; AL022808; E3 ubiquitin-protein ligase UHRF1; fb97f09; FLJ21925; hNP95; Hnp95 Huhrf1; hUHRF1; HuNp95; ICBP90; inverted CCAAT box-binding protein of 90 kDa; Liver regeneration-related protein LRRG126; MGC138707; mUhrf1; Np95; nuclear phosphoprotein 95; nuclear protein; nuclear protein 95; Nuclear zinc finger protein Np95; RING finger protein 106; RING-type E3 ubiquitin transferase UHRF1; RNF106; TDRD22; transcription factor ICBP90; ub; ubiquitin like with PHD and ring finger domains 1; ubiquitin-like PHD and RING finger domain-containing protein 1; ubiquitin-like with PHD and ring finger domains 1; ubiquitin-like, containing PHD and RING finger domains, 1; ubiquitin-like-containing PHD and RING finger domains protein 1; Uhrf1; unm b1115; unm_b1115; wu:fb97f09; zgc:63539 |
| Gene Symbols | UHRF1 |
| Show More |
Safety and Handling
By clicking Submit, you acknowledge that you may be contacted by Fisher Scientific in regards to the feedback you have provided in this form. We will not share your information for any other purposes. All contact information provided shall also be maintained in accordance with our Privacy Policy.